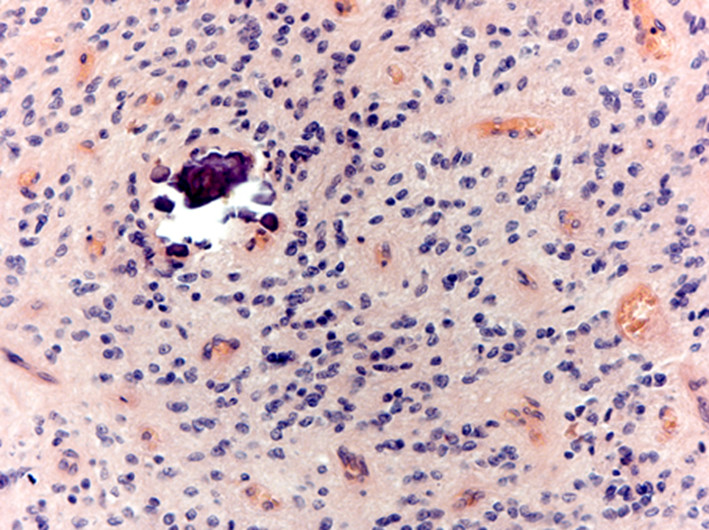
infographic

Wyszukaj egzamin lub pytanie
Egzamin PESNeurologia / jesień 2015
120 pytań
Pytanie 1
Wskaż fałszywe stwierdzenie dotyczące SM:
Pytanie 2
Wskaż prawdziwe stwierdzenia dotyczące SM:
1) ogniska demielinizacji mogą występować okołokomorowo;
2) reakcja immunologiczna jest poliklonalna i skierowana przeciwko kilku antygenom;
3) na terenie ognisk demielinizacji obecne są limfocyty B;
4) czynniki genetyczne warunkują podatność na rozwój demielinizacji;
5) połóg nie ma wpływu na aktywność choroby.
Prawidłowa odpowiedź to:
Pytanie 3
U pacjenta lat 30 stwierdzono pozagałkowe zapalenie nerwu wzrokowego. Badanie NMR wykazało prawidłowy obraz mózgowia. Prawdopodobieństwo rozwoju SM w tym przypadku wynosi:
Pytanie 4
Które spośród niżej wymienionych objawów rzadziej niż inne widywane są w przebiegu stwardnienia rozsianego?
1) zespół niespokojnych nóg;
2) zaburzenia funkcji poznawczych;
3) zaburzenia gałkoruchowe;
4) połowiczy kurcz twarzy;
5) zespół przewlekłego zmęczenia.
Prawidłowa odpowiedź to:
Pytanie 5
Który z poniżej podanych leków stosowanych w rzutowo-remisyjnej postaci SM może powodować powikłania w postaci postępującej wieloogniskowej leukoencefalopatii?
Pytanie 6
Wskaż prawdziwe stwierdzenia dotyczące odchyleń w badaniach laboratoryjnych w stwardnieniu rozsianym:
1) u ponad 60% chorych występuje nieprawidłowa liczba limfocytów;
2) prążki oligoklonalne występują w płynie mózgowo-rdzeniowym u około 90% chorych;
3) stężenie IgG w płynie mózgowo-rdzeniowym podwyższone jest u około 70% pacjentów;
4) nieprawidłowe potencjały wzrokowe wykrywa się u ponad 80% chorych;
5) obrazy T2 zależne są nieprawidłowe u około 90% chorych.
Prawidłowa odpowiedź to:
Pytanie 7
U 30-letniego chorego wystąpiły objawy pod postacią pozagałkowego zapalenia nerwu wzrokowego. W badaniu NMR stwierdzono 1 ognisko hiperintensywne T2 położone okołokomorowo i jedno ognisko hiperintensywne T2 położone podnamiotowo. U w/w pacjenta:
Pytanie 8
Wśród następujących jednostek chorobowych wskaż te, które wymagają różnicowania ze stwardnieniem rozsianym:
1) neuroborelioza;
2) choroba Behceta;
3) guzkowe zapalenie wielotętnicze;
4) toczeń układowy;
5) kiła układu nerwowego.
Prawidłowa odpowiedź to:
Pytanie 9
Wskaż prawdziwe stwierdzenia dotyczące leczenia stwardnienia rozsianego:
1) w ostrym rzucie choroby przy nieskuteczności steroidów stosuje się plazmaferezę;
2) powikłaniem leczenia mitoksantronem może być ostra białaczka;
3) natalizumab podaje się w dawce 100 mg/dobę przez 5 dni;
4) tizanidynę stosuje się w zaburzeniach zwieraczy;
5) przeciwciała neutralizujące w czasie leczenia interferonem beta 1b pojawiają się u około 30% chorych.
Prawidłowa odpowiedź to:
Pytanie 10
Wskaż fałszywe stwierdzenia dotyczące terapii SM:
1) w trakcie leczenia interferonami mogą pojawić się zaburzenia czynności wątroby oraz niewydolność szpiku;
2) w przypadku długoterminowej terapii octanem glatirameru u chorych może dojść do martwicy tkanki tłuszczowej;
3) interferon beta 1 a i.m. podaje się w dawce 44 ug co drugi dzień;
4) mitoksantron ma działanie kardiotoksyczne;
5) w zespole przewlekłego zmęczenia stosuje się amantadynę.
Prawidłowa odpowiedź to:
Pytanie 11
Do pewnego rozpoznania mózgowej angiopatii amyloidowej (CAA) wg kryteriów bostońskich, niezbędne jest przede wszystkim:
Pytanie 12
Chłoniak mózgu obok toksoplazmozy, jest ważną przyczyną ogniskowych zmian w mózgu u chorych na:
Pytanie 13
W badaniu mikroskopowym chorego na postępujące porażenie nadjądrowe/zespół Steele’a-Richardsona-Olszewskiego (progressive supranuclear palsy, PSP) mogą występować następujące nieprawidłowości, z wyjątkiem:
Pytanie 14
W badaniu neuropatologicznym mózgu, obserwowano zanik płatów czołowych i skroniowych, z masywnymi ubytkami neuronów i glejozą odczynową. Występowały liczne achromatyczne neurony oraz charakterystyczne srebrochłonne, tau dodatnie ciała w neuronach kory i zakrętu zębatego hipokampa, zwane ciałami:

Pytanie 15
W encefalopatii wątrobowej w wyniku obniżenia poziomu glutaminianu, następuje uszkodzenie morfologiczne pewnego typu komórek OUN. Zmienione morfologicznie komórki nazywamy komórkami Alzheimera typu II, zwanymi także „nagimi jądrami”. Zmiany te dotyczą następującego typu komórek:

Pytanie 16
W encefalopatii paranowotworowej następuje znaczne przerzedzenie przede wszystkim następującej warstwy kory:

Pytanie 17
Charakterystycznymi elementami obrazu neuropatologicznego choroby Creutzfeldta-Jakoba (CJD) są zmiany gąbczaste, ubytki neuronów, glejoza astrocytarna oraz blaszki dodatnio reagujące z następującym białkiem:

Pytanie 18
Neuropatologicznie guz jest bogatokomórkowy o małym pleomorfizmie. Jądra okrągłe lub wydłużone z widocznymi jąderkami. Często występuje ułożenie komórek wokół naczyń (rzekome rozety) lub wokół centralnej szczeliny lub jamki (rozety prawdziwe). Niekiedy występują także zwapnienia. Według skali złośliwości WHO ten nowotwór może wykazywać II lub III stopień złośliwości. Opisany obraz morfologiczny odpowiada:
Pytanie 19
Choroba Alpersa (poliodystrophia progressiva) z początkiem choroby powyżej 2 roku życia z oporną na leczenie padaczką, upośledzeniem psychoruchowym, ślepotą i głuchotą należy do chorób:
Pytanie 20
Obrzęk mózgu naczyniopochodny, od obrzęku cytotoksycznego (metabolicznego) mózgu różni się uszkodzeniem:
Pytanie 21
Dziedziczną chorobą zwyrodnieniową, w której występuje dystonia jest:
Pytanie 22
Wskaż prawdziwe stwierdzenie dotyczące choroby Huntingtona:
Pytanie 23
Do dystonii nie należy/ą:
Pytanie 24
Stosowanie amantadyny u osoby z chorobą Parkinsona może powodować niżej wymienione, z wyjątkiem:
Pytanie 25
W drżeniu samoistnym można stwierdzić niżej wymienione objawy, z wyjątkiem:
Pytanie 26
Kryteria diagnostyczne postępującego porażenia nadjądrowego obejmują stwierdzenie u chorego niżej wymienionych, z wyjątkiem:
Pytanie 27
„Miorytmie szkieletowe i oczno-twarzowe” są patognomomiczne dla:
Pytanie 28
Objawy neurologiczne związane pierwotnie z zakażeniem HIV (ostre) to niżej wymienione, z wyjątkiem:
Pytanie 29
Bóle strzelające, ataksja, nieprawidłowości źrenic są charakterystyczne dla:
Pytanie 30
Triada Hutchinsona to:
1) wodogłowie;
2) śródmiąższowe zapalenie rogówki;
3) deformacja zębów;
4) utrata słuchu;
5) wiąd rdzenia.
Prawidłowa odpowiedź to:
Pytanie 31
Wymienione cechy obrazu klinicznego choroby Parkinsona są prawdziwe, z wyjątkiem:
Pytanie 32
Mioklonie mogą występować w przebiegu wielu schorzeń i są trudne do leczenia. Wskaż prawdziwe stwierdzenie dotyczące zespołów mioklonicznych:
Pytanie 33
Które z wymienionych schorzeń nie jest dystonią?
Pytanie 34
W kwalifikacji chorego z chorobą Parkinsona do zabiegu głębokiej stymulacji mózgu należy wziąć pod uwagę wiele czynników. Wskazania do zabiegu istnieją w przypadku:
1) zachowanej reakcji na lewodopę;
2) braku nasilonych zaników korowo-podkorowych;
3) braku nasilonych zmian w istocie białej mózgu;
4) braku nasilonej depresji (depresja stanu off nie jest przeciwwskazaniem);
5) braku otępienia (łagodne nie jest przeciwwskazaniem);
6) wieku poniżej 80 lat;
7) występowania fluktuacji i dyskinez;
8) występowania napadów przymrożenia i upadków;
9) stosowania terapii farmakologicznej, która nie przynosi poprawy;
10) co najmniej 3 lat trwania choroby.
Prawidłowa odpowiedź to:
Pytanie 35
Do neurologa został skierowany chory lat 70 z drżeniem kończyn górnych (P>L), uniemożliwiającym mu całkowicie pisanie oraz posługiwanie się sztućcami. Dodatkowo, żona zauważyła u niego drżenie głowy o charakterze przeczenia. Objawy pogarszają się stopniowo od 6 lat. Dodatkowo chory cierpi na obniżenie nastroju, źle kontrolowaną cukrzycę oraz astmę oskrzelową. Prawidłowe rozpoznanie i postępowanie w tym schorzeniu charakteryzuje następujące zdanie:
Pytanie 36
Do objawów nasuwających podejrzenie zwyrodnienia korowo-podstawnego należą wszystkie wymienione, z wyjątkiem:
Pytanie 37
Pląsawica może być objawem polietiologicznym i trudnym do leczenia:
1) może wystąpić w przebiegu ciąży;
2) może być objawem stosowania leków antykoncepcyjnych oraz przeciwpadaczkowych np. fenytoiny i karbamazepiny;
3) może przebiegać z obecnością akantocytów w rozmazie krwi;
4) może być objawem tocznia układowego;
5) w chorobie Huntingtona występuje zazwyczaj przy zwiększeniu ilości powtórzeń CAG > 60;
6) jest szczególnie nasilona w młodzieńczej postaci choroby Huntingtona;
7) tetrabenazyna to jedyny zarejestrowany lek w leczeniu pląsawicy w przebiegu choroby Huntingtona;
8) w chorobie Huntingtona pląsawicy towarzyszy często depresja, ale myśli samobójcze są stosunkowo rzadkie.
Prawidłowa odpowiedź to:
Pytanie 38
Zespół Westa charakteryzuje się:
1) napadami nieświadomości;
2) napadami padaczkowymi uogólnionymi z napadami skłonów;
3) początkiem pomiędzy 1-5 rokiem życia;
4) początkiem w ciągu pierwszych 6 miesięcy życia;
5) zespołem uwarunkowanym genetycznie;
6) najczęściej padaczką objawową.
Prawidłowa odpowiedź to:
Pytanie 39
Młodzieńcza padaczka miokloniczna charakteryzuje się:
1) obustronnymi iglicami 3Hz w EEG;
2) obustronnymi zespołami iglica-fala wolna 4-6 Hz i zespołami wieloiglic;
3) prawidłowym rozwojem umysłowym;
4) opóźnieniem rozwoju umysłowego;
5) padaczką uwarunkowaną genetycznie;
6) padaczką objawową.
Prawidłowa odpowiedź to:
Pytanie 40
Wymień leki przeciwpadaczkowe o wąskim spektrum terapeutycznym:
1) karbamazepina;
2) kwas walproinowy;
3) zonisamid;
4) lamotrygina;
5) etosuksymid;
6) lewetyracetam.
Prawidłowa odpowiedź to:
Pytanie 41
Wskaż prawdziwe stwierdzenia dotyczące wpływu hormonów płciowych na próg drgawkowy:
1) hormony płciowe nie mają wpływu na próg drgawkowy;
2) estrogeny wykazują działanie prodrgawkowe;
3) estrogeny wykazują działanie przeciwdrgawkowe;
4) progesteron wykazuje działanie prodrgawkowe;
5) progesteron wykazuje działanie przeciwdrgawkowe.
Prawidłowa odpowiedź to:
Pytanie 42
Agoniści dopaminy to często stosowana grupa leków, którą najlepiej charakteryzują następujące opisy:
1) mają zastosowanie w leczeniu zespołu niespokojnych nóg;
2) powodują obrzęki goleni;
3) mogą powodować patologiczny hazard;
4) są przyczyną nagłych zaśnięć;
5) powodują zmiany na skórze o typie livedo reticularis;
6) bardziej niż lewodopa mogą wyzwalać występowanie omamów;
7) powodują okresowe wzrosty ciśnienia tętniczego;
8) mogą być stosowane w leczeniu gruczolaka przysadki;
9) nowej generacji - nie powodują zwłóknienia zastawek serca.
Prawidłowa odpowiedź to:
Pytanie 43
Otępienie jest częstym elementem obrazu klinicznego różnych schorzeń neurodegeneracyjnych, z wyjątkiem:
Pytanie 44
Do lekarza zgłosił się chory lat 65 z rozpoznaniem choroby Parkinsona i astmą oskrzelową. Od około 6 lat występuje u niego nasilone drżenie początkowo prawej, a od 2 lat także lewej kończyny górnej, głównie dystalne, które nie poprawia się po podaniu lewodopy. Po jej podaniu chory jednak lepiej chodzi i nie ma sztywności mięśni, ale tylko przez około 2,5 godziny. Lek zażywa 3 razy na dobę w dawce 125mg oraz 125mg w postaci o przedłużonym działaniu na noc. Dodatkowo, od początku choroby przyjmuje selegilinę 2x5mg. Od roku, chory w godzinach rannych jest senny, po wstaniu z łóżka lub fotela odczuwa szum w głowie i mroczki przed oczami. Żona zauważyła, że od pół roku śpi niespokojnie, ma koszmary nocne, po obudzeniu w nocy widzi nieżyjącego brata. Najwłaściwsze postępowanie u niego to:
Pytanie 45
Leki przeciwpadaczkowe, które nie zaburzają działania leków antykoncepcyjnych to:
1) kwas walproinowy;
2) karbamazepina;
3) tiagabina;
4) fenytoina;
5) lewetyracetam;
6) okskarbazepina.
Prawidłowa odpowiedź to:
Pytanie 46
Przypadek kliniczny: od około 16 roku życia występują epizody zaburzeń ruchowych o charakterze szybkich, gwałtownych ataków pedałowania nogami, wypychania miednicy z wokalizacją. Występują głównie w nocy. W EEG wykonanym w okresie międzynapadowym nie uwidoczniono zmian patologicznych. Pacjent nie pamięta co się z nim działo po epizodzie. Prawdopodobne rozpoznanie to:
Pytanie 47
Przypadek kliniczny: w wywiadzie przebyty stan padaczkowy drgawkowy jako pierwsza manifestacja choroby w wieku 8 r.ż. Obecnie, w wieku 12 lat stwierdza się niedowład połowiczy lewostronny, utrzymujące się stale drgawki w zakresie mięśni lewej połowy twarzy. W badaniu MRI głowy cechy zaniku korowego w prawej półkuli mózgu i rozległej glejozy. Najbardziej prawdopodobna diagnoza:
Pytanie 48
Zaburzenia psychopatologiczne związane z padaczką:
1) najczęściej charakteryzują się występowaniem w okresie bezpośrednio ponapadowym;
2) najczęściej występują w okresie międzynapadowym;
3) mogą stanowić behawioralną manifestację porażenia Todda;
4) zwykle są łagodne i nie wymagają leczenia;
5) występują tylko u osób z współistniejącą chorobą psychiczną.
Prawidłowa odpowiedź to:
Pytanie 49
Wskaż leki przeciwpadaczkowe, których stosowanie nie wiąże się z ryzykiem osteoporozy:
1) karbamazepina;
2) gabapentyna;
3) kwas walproinowy;
4) zonisamid;
5) fenytoina;
6) lewetyracetam.
Prawidłowa odpowiedź to:
Pytanie 50
Leki przeciwpadaczkowe, które obniżają łaknienie i mogą wiązać się z utratą masy ciała to:
1) topiramat;
2) karbamazepina;
3) zonisamid;
4) kwas walproinowy;
5) felbamat;
6) gabapentyna.
Prawidłowa odpowiedź to:
Pytanie 51
Podczas napadu klasterowego bólu głowy nie występuje/ą:
Pytanie 52
W leczeniu klasterowego bólu głowy najskuteczniejsze jest podawanie:
Pytanie 53
W neuralgii trójdzielnej nie występuje/ą:
Pytanie 54
Do zajęcia mózgu może dość w przypadku oponiaka:
Pytanie 55
Zespół opsoklonie - mioklonie zalicza się do:
Pytanie 56
Skąpodrzewiaki od innych nowotworów pochodzenia glejowego wyróżnia:
Pytanie 57
Pierwotne chłoniaki ośrodkowego układu nerwowego zbudowane są z:
Pytanie 58
Najczęściej przerzuty do mózgu dają:
Pytanie 59
Wskaż prawdziwe stwierdzenia dotyczące nowotworów okolicy siodła tureckiego:
1) najczęściej w tej okolicy występują oponiaki, czaszkogardlaki i gruczolaki przysadki;
2) oponiaki wyrostka pochyłego przedniego powodują w pierwszej kolejności postępującą utratę wzroku;
3) w fazie nadnamiotowej gruczolaka przysadki pierwsze objawy związane są z zajęciem zatoki jamistej;
4) jednym z pierwszych objawów gruczolaka wydzielającego prolaktynę jest mlekotok, niezależnie od płci;
5) guzy wydzielające ACTH często osiągają rozmiary makrogruczolaka.
Prawidłowa odpowiedź to:
Pytanie 60
Do objawów klinicznych czaszkogadlaka, rozwijającego się u dorosłych nie należą:
1) spadek libido;
2) niepokój lub pobudzenie;
3) nietrzymanie moczu;
4) niskorosłość;
5) opóźnienie dojrzewania płciowego.
Prawidłowa odpowiedź to:
Pytanie 61
Nowotwory ośrodkowego układu nerwowego w okresie płodowym charakteryzuje:
1) w przeważającej części przypadków lokalizacja nadnamiotowa;
2) częste usadowienie w strukturach linii środkowej;
3) występowanie w pierwszym trymestrze ciąży;
4) ryzyko przyspieszonego rozrostu guza pod koniec ciąży;
5) w większości przypadków dobre rokowanie w okresie poporodowym.
Prawidłowa odpowiedź to:
Pytanie 62
Do objawów klinicznych guzów zewnątrzrdzeniowych nie należą:
1) bóle dermatomalne;
2) osłabienie odruchów głębokich na wysokości guza;
3) rozszczepiennie zaburzenia czucia typu „kubraczka”;
4) parestezje o lokalizacji korzeniowej;
5) wczesne zaburzenia zwieraczy.
Prawidłowa odpowiedź to:
Pytanie 63
Ryzyko krwotoku śródczaszkowego wzrasta w wyniku:
1) stosowania kwasu acetylosalicylowego (ASA) u chorych z nadciśnieniem tętniczym;
2) połączenia ASA z klopidogrelem w profilaktyce wtórnej u chorych z dużym ryzykiem nawrotowych incydentów niedokrwiennych;
3) zastosowania innych niż ASA leków przeciwpłytkowych;
4) stosowania ASA przed dożylnym podaniem rekombinowanego aktywatora plazminogenu;
5) zastosowania ASA w udarze na tle choroby małych naczyń.
Prawidłowa odpowiedź to:
Pytanie 64
Objawy krwotoku do półkuli móżdżku to:
1) tożstronne bóle głowy;
2) przeciwstronna niezborność;
3) zaburzenia równowagi z tendencją do padania w stronę przeciwną;
4) mowa skandowana;
5) zawroty głowy, wymioty.
Prawidłowa odpowiedź to:
Pytanie 65
Leczenie zakrzepicy żylnej mózgu polega na:
1) stosowaniu spośród heparyn jedynie postaci drobnocząsteczkowej;
2) podawaniu bolusa heparyny nie dłużej niż 7 dni;
3) utrzymywaniu podczas podawania bolusa przynajmniej 3-krotnie wydłużonego czasu kaolinowo-kefalinowego (aPTT);
4) rozważeniu zastosowania leczenia trombolitycznego w stanach ciężkich;
5) stosowaniu leków przeciwzakrzepowych od 6 do 12 miesięcy u chorych z idiopatyczną postacią zakrzepicy.
Prawidłowa odpowiedź to:
Pytanie 66
Wzrost ryzyka rozwoju padaczki nie jest związany z:
Pytanie 67
Złe rokowanie co do całkowitego ustąpienia napadów padaczkowych nie dotyczy:
Pytanie 68
Do uogólnionych napadów padaczkowych nie należą napady:
Pytanie 69
Napady padaczkowe z płata czołowego mają następujące cechy, z wyjątkiem:
Pytanie 70
Do cech atypowych napadów nieświadomości nie należy:
Pytanie 71
Wskaż fałszywe stwierdzenie dotyczące padaczki menstruacyjnej:
Pytanie 72
Ważnym czynnikiem ryzyka nawrotu napadów padaczkowych nie jest/nie są:
Pytanie 73
Wskaż fałszywe stwierdzenie dotyczące napadów gorączkowych:
Pytanie 74
Wskaż fałszywe stwierdzenie dotyczące łagodnej padaczki rolandycznej:
Pytanie 75
Dla neuropatii demielinizacyjnej charakterystyczne są:
Pytanie 76
Wskaż prawdziwe stwierdzenie dotyczące dziedzicznej neuropatii z nadwrażliwością na ucisk:
1) jest chorobą alleliczną z CMT1A (choroba Charcota-Mariego-Tootha typu 1A);
2) jest wywołana delecją w genie białka PMP22;
3) jest wywołana mutacją w genie MP0 (myelin protein zero);
4) jest dziedziczona autosomalnie dominująco;
5) jest dziedziczona autosomalnie recesywnie;
6) charakterystycznym objawem towarzyszącym porażeniu nerwu obwodowego jest ból.
Prawidłowa odpowiedź to:
Pytanie 77
Do cech różnicujących zespół Guillaina-Barrego i przewlekłą zapalną polineuropatię demielinizacyjną należą:
1) czas narastania objawów;
2) symetryczny niedowład kończyn ze zniesieniem lub osłabieniem odruchów;
3) objawy uszkodzenia autonomicznego układu nerwowego;
4) występowanie chorób poprzedzających wystąpienie objawów takich jak choroba zakaźna, szczepienie lub operacja;
5) korzystny wpływ stosowania plazmaferez;
6) dobra reakcja na zastosowanie kortykosteroidów.
Prawidłowa odpowiedź to:
Pytanie 78
Wskaż prawdziwe stwierdzenia dotyczące polineuropatii w przebiegu zespołów paranowotworowych:
1) najczęściej występuje w przebiegu raka drobnokomórkowego płuc;
2) najczęściej występuje w przebiegu nowotworów okrężnicy;
3) najczęstszą neuropatią jest podostra polineuropatia czuciowa;
4) najczęstszą neuropatią jest przewlekła neuropatia czuciowo-ruchowa;
5) najczęściej stwierdza się autoprzeciwciała typu anty-Hu;
6) w leczeniu wykorzystuje się plazmaferezy i dożylne wlewy immunoglobulin.
Prawidłowa odpowiedź to:
Pytanie 79
Wskaż prawdziwe stwierdzenia dotyczące zespołu post-polio:
1) określany jest jako osłabienie i zanik występujące w grupach mięśni niezajętych uprzednio przez polio;
2) występuje po co najmniej 5 latach stabilnego stanu klinicznego;
3) występuje po co najmniej 15 latach stabilnego stanu klinicznego;
4) często objawem towarzyszącym jest ból mięśni i uczucie zmęczenia;
5) często zespołowi towarzyszą objawy uszkodzenia górnego neuronu ruchowego;
6) opisywano korzystny wpływ stosowania dożylnych wlewów immunoglobulin.
Prawidłowa odpowiedź to:
Pytanie 80
Do charakterystycznych cech choroby Kennedy’ego (zanik mięśni rdzeniowo-opuszkowy) należą wszystkie wymienione, z wyjątkiem:
Pytanie 81
Do cech wspólnych charakteryzujących dystrofię miotoniczną typu 1 i dystrofię miotoniczną typu 2 należą:
1) obecność miotonii;
2) osłabienie proksymalne kończyn dolnych;
3) osłabienie dystalne kończyn górnych;
4) występowanie zaćmy;
5) przerost łydek;
6) występowanie postaci wrodzonej.
Prawidłowa odpowiedź to:
Pytanie 82
Wskaż fałszywe stwierdzenie dotyczące dystrofii mięśniowej postępującej typu Beckera:
Pytanie 83
Dla miopatii mitochondrialnych charakterystyczne są wszystkie wymienione cechy, z wyjątkiem:
Pytanie 84
Najczęstszą postacią otępienia u chorych ze sporadyczną postacią stwardnienia bocznego zanikowego jest:
Pytanie 85
W odniesieniu do zespołu niespokojnych nóg nieprawdą jest, że:
Pytanie 86
U 58-letniej kobiety, dotychczas nie leczącej się przewlekle, od ok. 4 lat stopniowo narasta niesprawność ruchowa. Według córki początkowo skarżyła się na pogorszenie widzenia, pojawiły się trudności w poruszaniu się - kilka razy upadła bez wyraźnej przyczyny, jest znacznie wolniejsza w codziennych czynnościach, mówi coraz mniej zrozumiale, od pewnego czasu krztusi się przy posiłkach. W badaniu stwierdzasz m.in.: zaburzenia ruchomości gałek ocznych w pionie, bardzo nasiloną dyzartrię, znaczne spowolnienie, sztywność osiową, wzmożone plastycznie napięcie w 4 kończynach. Jako najbardziej prawdopodobne rozpoznanie przyjmiesz:
Pytanie 87
U 53-letniego mężczyzny od kilku lat stopniowo narastają objawy niesprawności ruchowej, zaburzeń równowagi, mowy. Początkowo wielokrotnie traktowano go, jak pijanego. Od kilku miesięcy porusza się na wózku inwalidzkim, występują zaburzenia połykania. Podobne objawy miał jego nieżyjący już ojciec i brat ojca, u których jednak nie postawiono konkretnego rozpoznania. W badaniu stwierdzasz m.in.: oczopląs grubofalisty do boków i ograniczenie ruchów gałek ocznych w pionie, znaczną dyzartrię, fascykulacje mięśni języka, ataksję w 4 kończynach z obniżonym napięciem mięśniowym, zniesione dystalnie odruchy głębokie. Z poniższych propozycji, najbardziej prawdopodobnym rozpoznaniem jest:
Pytanie 88
Zaburzenia ruchów gałek ocznych i objawy parkinsonizmu stwierdza się w wielu chorobach neurozwyrodnieniowych, z wyjątkiem:
Pytanie 89
43-letnia kobieta od ok. 2 lat zachowuje się - w relacji męża - dziwacznie. Nie może usiedzieć, czy stać spokojnie, stała się też wybuchowa, mniej uwagi poświęca domowi i dziecku tłumacząc się zmęczeniem i niemiłą atmosferą w pracy. Dotychczas się nie leczyła. Matka choruje na nadciśnienie tętnicze, ojciec zginął przed 20 laty w wypadku samochodowym, który spowodował pod wpływem alkoholu. W badaniu stwierdzasz: ruchy pląsawicze obejmujące całe ciało, dyzartria, obniżone napięcie mięśniowe w 4 kończynach, bez objawów patologicznych. W diagnostyce różnicowej, za najbardziej prawdopodobną uznasz:
Pytanie 90
Apraksja powiek może pojawić się w przebiegu wielu chorób neurozwyrodnieniowych. W przypadku jej wystąpienia najskuteczniejszym jest zastosowanie:
Pytanie 91
Choremu z zespołem niespokojnych nóg nie zalecisz:
Pytanie 92
Objawy parkinsonizmu w przebiegu chorób neurozwyrodnieniowych innych, niż choroba Parkinsona, zwykle występują od początku obustronnie, z wyjątkiem:
Pytanie 93
Obecnie warunkiem koniecznym do uruchomienia podstawowego oddziału udarowego zgodnie z zaleceniami Europejskiej Organizacji Udarowej oraz Deklaracji Helsingborgskiej jest:
Pytanie 94
Wskaż prawdziwe stwierdzenie dotyczące leczenia udaru niedokrwiennego mózgu:
Pytanie 95
Na poziomie opieki przedszpitalnej - zespół wyjazdowy pogotowia ratunkowego, w przypadku stwierdzenia objawów wskazujących na możliwość wystąpienia udaru mózgu, jak np. nagły niedowład połowiczy i afazja, po zabezpieczaniu (jeżeli jest taka potrzeba) podstawowych czynności życiowych powinien:
1) możliwie jak najdokładniej ustalić czas wystąpienia objawów udaru (poprzez wywiad od świadków, rodziny itd.) i odnotować to w dokumentacji;
2) ustalić jakie leki chory przyjmował i odnotować to w dokumentacji;
3) ustalić choroby współistniejące oraz przebyte zabiegi operacyjne i odnotować to w dokumentacji;
4) założyć kontakt dożylny i kontynuować powolny wlew soli fizjologicznej;
5) podać jak najszybciej (jeżeli chory jest przytomny) kwas acetylosalicylowy w dawce 300 mg doustnie;
6) podać dożylnie lub pod język leki obniżające ciśnienie tętnicze jeżeli wynosi ono ponad 185 mmHg (skurczowe) lub 110 mmHg (rozkurczowe).
Prawidłowa odpowiedź to:
Pytanie 96
Wskaż prawdziwe stwierdzenie dotyczące złośliwego obrzęku mózgu w przebiegu udaru niedokrwiennego:
Pytanie 97
Do czynności, które powinny być rutynowo wykonane u każdego chorego z podejrzeniem udaru mózgu zaraz po przyjęciu do szpitala należą:
Pytanie 98
Chorą w wieku lat 28, która dotąd nie rodziła, przyjęto do szpitala z powodu tętniących bólów głowy o znacznym natężeniu, z nudnościami i światłowstrętem trwających ponad 4 godziny, niedowładu połowiczego lewostronnego, zaburzeń świadomości, a następnie napadu padaczkowego uogólnionego drgawkowego toniczno-klonicznego. W badaniach laboratoryjnych stwierdzono dodatni test w kierunku kiły (VDRL), obecność przeciwciał przeciwko beta-2-glikoproteinie oraz przeciwciał skierowanych przeciw kompleksowi czynnika Xa i kardiolipinie. U tej pacjentki należy przede wszystkim podejrzewać:
Pytanie 99
Wskaż cechy charakterystyczne dla zakrzepicy żylnej mózgu:
1) rzadziej stwierdzany niż w udarach niedokrwiennych ból głowy;
2) częściej niż w udarze niedokrwiennym mózgu stwierdza się napady padaczkowe;
3) częściej występuje przebieg ostry niż podostry;
4) zajęcie wyłącznie jednej półkuli mózgu;
5) w badaniu płynu mózgowo-rdzeniowego w około połowie przypadków występuje nieznaczna pleocytoza;
6) stwierdzono, że prawidłowy wynik stężenia D-dimerów we krwi praktycznie wyklucza zakrzepicę żylną mózgu;
7) najbardziej przydatne techniki rezonansu magnetycznego w diagnostyce zakrzepicy żylnej mózgu to: GRE (Gradient-Echo) i SWI (Susceptibility weighted imaging).
Prawidłowa odpowiedź to:
Pytanie 100
Wskaż prawdziwe stwierdzenie dotyczące udaru niedokrwiennego mózgu:
Pytanie 101
W przypadku podejrzenia krwotoku podpajęczynówkowego:
1) prawidłowy wynik badania angiografii tomografii komputerowej (angio-KT) wyklucza obecność tętniaka;
2) w przypadku braku potwierdzenia patologii w badaniu obrazowym, a przy istniejących objawach w badaniu przedmiotowym należy uzupełnić diagnostykę o badanie płynu mózgowo-rdzeniowego;
3) najczulszym badaniem w wykrywaniu tętniaka naczyń mózgowych jest czteronaczyniowa angiografia cyfrowa subtrakcyjna (DSA);
4) celowe jest wykonywanie badania metodą czteronaczyniowej angiografii cyfrowej subtrakcyjnej w pewnym odstępie czasu np. po 2 tygodniach jeżeli pierwsze badanie nie wykazało tętniaka;
5) badanie tomografii komputerowej wykazuje taką samą czułość w zakresie obrazowania krwi w przestrzeniach płynowych w każdym dniu, w czasie pierwszych trzech dni od krwotoku, w kolejnych dniach czułość tego badania stopniowo ulega zmniejszeniu;
6) w analizie płynu mózgowo-rdzeniowego, w przypadkach wątpliwych pomocna jest zasada mówiąca, że stosunek liczby krwinek białych do czerwonych w płynie mózgowo-rdzeniowym w krwotoku podpajęczynówkowym wynosi około 1: 300.
Prawidłowa odpowiedź to:
Pytanie 102
Cechą charakterystyczną gruźliczego zapalenia opon mózgowych nie jest:
Pytanie 103
Do zespołu wklinowania w otwór wielki należą objawy, z wyjątkiem:
Pytanie 104
Nerwiakowłókniakowatość typu I dziedziczy się:
Pytanie 105
Związek procesu nowotworowego ustalono z następującymi zespołami:
Pytanie 106
Do cech wspólnych zespołu Guillaina-Barre`go i zespołu Millera-Fishera należą:
1) infekcje górnych dróg oddechowych poprzedzające wystąpienie objawów;
2) zajęcie mięśni twarzy;
3) podwyższony poziom białka w płynie mózgowo-rdzeniowym;
4) arefleksja;
5) zaburzenia źreniczne;
6) osłabienie kończyn.
Prawidłowa odpowiedź to:
Pytanie 107
Napady nieświadomości:
1) dobrze reagują na karbamazepinę;
2) mogą występować setki razy na dobę;
3) zwykle rozpoczynają się w dzieciństwie lub wczesnej młodości;
4) charakteryzują się ogniskowymi wyładowaniami w EEG;
5) dobrze reagują na leczenie określonymi lekami przeciwpadaczkowymi.
Prawidłowa odpowiedź to:
Pytanie 108
Leczenie napadów padaczkowych powinno:
1) uwzględniać typ napadów;
2) być dobrane indywidualnie dla pacjenta;
3) uwzględniać różnice w skuteczności i toksyczności leków przeciwpadaczkowych w odniesieniu do każdego pacjenta;
4) uwzględniać jedynie toksyczność leków przeciwpadaczkowych;
5) być dobrane indywidualnie wyłącznie u dzieci.
Prawidłowa odpowiedź to:
Pytanie 109
Badaniem diagnostycznym sarkoidozy ośrodkowego układu nerwowego jest:
Pytanie 110
W leczeniu choroby Whipple’a stosuje się:
1) tetracykliny;
2) trimetoprim-sulfametoksazol;
3) izoprynozynę;
4) izoniazyd;
5) penicilinę.
Prawidłowa odpowiedź to:
Pytanie 111
Przyczyną zespołu Leigha jest niedobór:
Pytanie 112
W badaniu 27-latka leczonego psychiatrycznie z powodu zaburzeń zachowania stwierdza się m.in.: ruchy mimowolne o charakterze pląsawicy głównie w zakresie kończyn górnych, tułowia, dyzartrię. Rodzice pacjenta nie żyją - zginęli w wypadku samochodowym, dziadek ze strony matki miał się dziwacznie poruszać i mieć kłopoty z pamięcią. Najbardziej prawdopodobne podejrzenie to:
Pytanie 113
40-letnia kobieta zgłosiła się z objawami kręczu karku. Rozpatrując przyczyny wtórnej dystonii, najmniej przydatne jest wykonanie:
Pytanie 114
Najczęstszą przyczyną otępienia jest:
Pytanie 115
U 75-letniej chorej z narastającymi zaburzeniami poznawczymi i kilkoma epizodami udarowymi w wywiadzie, w tym o charakterze niedokrwiennym i krwotocznym, podczas kolejnego udaru stwierdzono otępienie i pogłębienie niedowładu lewych kończyn. W pierwszej kolejności należy uwzględnić:
Pytanie 116
U 53-letniej kobiety pojawiły się stopniowo narastające bóle pleców, zwłaszcza w nocy, w pozycji leżącej. Po kilku tygodniach dołączyło się osłabienie prawej kończyny dolnej. W pierwszej kolejności należy myśleć o:
Pytanie 117
Spośród chorób spichrzeniowych objawy podobne do rdzeniowego zaniku mięśni mogą wstępować w:
Pytanie 118
Do schorzeń dysmielinizacyjnych należy:
Pytanie 119
W malformacji Dandy-Walkera nie występuje:
Pytanie 120

